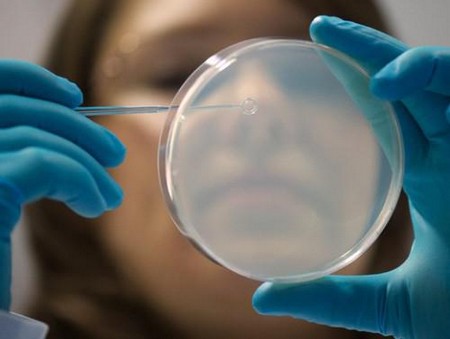

Сучасна екологія, постійні стреси , божевільний ритм життя і багато інших чинників неминуче накладають відбиток на стан нашого здоров'я, причому найчастіше організм сигналізує нам про своє виснаженні порушенням травлення, пов'язаних зі зміною складу нормальної мікрофлори. Саме тому лікування дисбактеріозу є однією з найбільш частих завдань сучасних гастроентерологів.
Особливості лікування
Лікування дисбактеріозу кишечника завжди носить комплексний характер, оскільки без усунення причини його розвитку, будь-які заходи щодо нормалізації кишкової мікрофлори будуть безрезультатними. Крім того, хворим необхідно звернути увагу на зміцнення захисних сил організму, так як саме зниження природного захисту створює умови для розмноження умовно-патогенних мікроорганізмів.
Тому і говорити про те, який лікар лікує дисбактеріоз кишечника, не завжди доречно, оскільки різним пацієнтам можуть бути потрібні консультації різних фахівців залежно від того, яка патологія стала причиною розвитку дисбактеріозу. Проте боротьбою саме з диспепсичними явищами і іншими порушеннями з боку шлунково-кишкового тракту, тобто безпосередньо проявами дисбактеріозу, займаються лікарі-гастроентерологи.
Увага! Спочатку пацієнтам варто усунути захворювання, що спричинило за собою розвиток дисбактеріозу і тільки після цього приступати до нормалізації стану мікрофлори кишечника.
Схема лікування дисбактеріозу включає в себе наступні етапи:
- ліквідація патогенної мікрофлори;
- заселення кишечника представниками нормальної мікрофлори;
- нормалізація травлення;
- досягнення балансу між умовно-патогенними і корисними бактеріями;
- корекція імунного статусу пацієнта.
Медикаментозне лікування
Оскільки тяжкість перебігу захворювання та вік хворих може бути різним, терапевтичні заходи підбирають в залежності від цих параметрів. Тому в легких ситуаціях буває досить змінити режим і склад харчування, приймати вітаміни, ентеросорбенти, пребіотики або пробіотики, а у важких випадках буває складно обійтися без використання такої важкої артилерії, як антибіотики, кишкові антисептики і бактеріофаги.
Пребиотики
Пребиотики представляють собою групу лікарських засобів, до складу яких входять речовини немікробного походження, що стимулюють природне зростання нормальної мікрофлори. Іншими словами, ці препарати у великих кількостях містять поживні для корисних мікроорганізмів компоненти. Тому в результаті їх вживання кількість корисних бактерій зростає, що спочатку перешкоджає розмноженню хвороботворних мікроорганізмів, а згодом і зовсім пригнічує їх ріст.

Лікування дисбактеріозу кишечника пребиотиками актуально для легких форм захворювання, але в той же час воно не вимагає створення будь-яких спеціальних умов, оскільки в нормі все полягають в них речовини потрапляють в організм з їжею, зокрема, з кукурудзою, цибулею, часником, молочними продуктами і тому подібним. До складу подібних препаратів входять:
- Неперетравлювані дисахариди;
- фруктоолігосахаріди;
- молочні кислоти тощо.
Прибуток
В цілому сьогодні складно розглядати питання про те, як позбавиться від дисбактеріозу кишечника, без згадки так званих пробіотиків. Про них нам кричать з екранів телевізора, рекламних щитів, сторінок преси. Вони являють собою лікарські засоби, що містять корисні живі мікроорганізми. Але ефективність подібних препаратів уже давно ставиться медиками під сумнів, так як всі вони призначені для перорального застосування, тому перш, ніж потрапити в кишечник, вони неминуче проходять через шлунок. Як відомо, в шлунку завжди зберігається агресивне середовище, створювана концентрованою соляною кислотою, тому більшість бактерій в ній гине.
Увага! Ефективність прийому пробіотиків сьогодні ставиться під сумнів авторитетними фахівцями в галузі медицини та фармакології.
Виробники роблять безліч спроб подолати цю проблему, зокрема, укладають ліофілізовані бактерії в нерозчинні в шлунковому соку оболонки, але гарантувати проникненні необхідних кількостей мікроорганізмів в потрібні відділи кишечника вони все ще не можуть. Проте пробіотики широко застосовуються для лікування і профілактики дисбактеріозу кишечника.
Виділяють наступні види цих препаратів:
- Полікомпонентні, до складу яких входить кілька різних видів бактерій, наприклад, біфідо-, лакто-і колібактерії.
- Монокомпонентні, до складу яких входить тільки один з перерахованих вище вид бактерій.
- Комбіновані, що включають компоненти живильного середовища, іммуноглобуліновие комплекси, симбіотичні співтовариства бактерій і окремі штами, нечутливі до дії більшості відомих сьогодні антибіотиків.
- Рекомбінантні, що містять крім традиційних штамів бактерій генномодифіковані.
- Синбіотики представляють собою препарати, в яких одночасно містяться і корисні бактерії, і субстрат для них, тобто такі лікарські засоби поєднують в собі компоненти пробіотиків і пребіотиків.
- Антагоністи. У цю групи відносяться препарати, що містять пригнічують ріст умовно-патогенної мікрофлори бактерії.
Антибактеріальна терапія
Якщо захворювання виявляється на тих етапах, коли вже не доводиться говорити про незначні відхилення від рівноваги між чисельністю корисних і умовно-патогенних бактерій, як лікувати дисбактеріоз буде вже залежати від результатів лабораторних досліджень. Саме дослідження чутливості виявлених в кишечнику мікроорганізмів до різних препаратів лежить в основі підбору методу лікування пацієнта.
Найчастіше застосовуються:
- антибіотики різних груп;
- нітрофуран;
- сульфаніламіди;
- протигрибкові засоби;
- протипротозойні і протимікробні препарати;
- бактеріофаги.
Важливо: бактеріофагами називають специфічні віруси, які здатні проникати всередину бактерій певного виду і руйнувати їх зсередини. Такі препарати в різних випадках можуть використовуватися самостійно або на додаток до антибактеріальної терапії, але приймати рішення про необхідність їх застосування повинен лікар.
Засоби допоміжної терапії
Уявити лікування дисбактеріозу у дорослих без призначення препаратів загальнозміцнюючий дії і усувають неприємні симптоми захворювання, пов'язані з порушенням травлення, неможливо, тому пацієнтам завжди призначаються:
- імуномодулятори;
- вітаміни;
- ентеросорбенти;
- ферментні препарати;
- спазмолітики;
- жовчогінні засоби;
- антигістамінні препарати.
Дієта
Дієта є невід'ємним компонентом лікування будь-якого захворювання шлунково-кишкового тракту, в тому числі і дисбактеріозу, оскільки без дотримання правил раціонального харчування відновлення нормальної мікрофлори неможливо. Тому всім хворим необхідно навчитися складати своє меню так, щоб воно було абсолютно збалансовано за вмістом білків, жирів і вуглеводів. Крім того, дуже важливо простежити за тим, щоб організм отримував всі необхідні йому вітаміни і мінерали в належних кількостях, а також не відчував дефіциту рідини. У зв'язку з цим хворим рекомендують випивати не менше двох літрів води на добу.
Порада: оптимальним варіантом є вживання пари склянок чистої води за півгодини до прийому їжі, причому краще віддати перевагу теплій негазованої мінералки.
у раціоні пацієнтів обов'язково повинні бути присутніми кисломолочні продукти, так як вони в великих кількостях містять корисні лакто-і біфідобактерії. Тому щодня потрібно вживати в чистому вигляді або у складі різних страв свіжі сир, сир, кефір, йогурт, вершкове масло, причому необхідно дуже уважно стежити за їх якістю і намагатися уникати продуктів, що містять пальмову олію, ароматизатори, консерванти та інші подібні речовини. Велику підтримку ШКТ надає прийом амінокислот, так як ці компоненти білків здатні надавати незначне лікувальну дію. Так, аргінін дає анаболічний і імуностимулюючий ефект, а глутамин служить джерелом високоенергетичних сполук, а також пурину і азоту.

Увага! Їжу варто вживати в один і той же час дрібно, тобто часто і невеликими порціями. Тому кількість щоденних трапез варто збільшити до п'яти.
Також обов'язковим компонентом щоденного меню повинні бути продукти, багаті на пектини і харчові волокна, наприклад:
- морква,
- буряк,
- висівки,
- морські водорості,
- капуста і так далі.
Важливо: для кожного пацієнта лікар в індивідуальному порядку підбирає дієту в залежності від характеру стільця, результатів копрограми і, отже, виду диспепсії (гнильної, бродильной і так далі).
Цікаво, що в деяких легких випадках навіть антибактеріальне лікування дисбактеріозу кишечника у дорослих може проводитися за допомогою певних продуктів харчування, так як для частини мікроорганізмів речовини, що містяться в тих чи інших продуктах, виявляються згубними. Наприклад:
- Кишкова паличка погано переносить компоненти солодкого перцю, граната і цибулі.
- Стафілокок можна винищити малиною, барбарисом, чорноплідної або червоною горобиною.
- Клебсієли, синьогнійна паличка, протей починають знижувати свою активність під впливом яблук, абрикоса, редьки, часнику, шавлії, чорниці, кропу, горобини і хрону.
- Грибки і особливо кандиди негативно сприймають речовини свіжої моркви і ягід брусниці.
На ряду з продуктами харчування для нормалізації кишкової мікрофлори можна застосовувати і засоби народної медицини, наприклад , продукти бджільництва та деякі рослини. Самі дієві рецепти, рекомендовані народними цілителями, ми зібрали в статті: